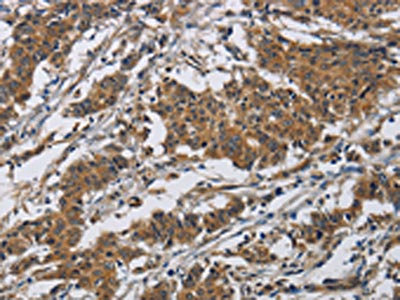

CLDN8 Antibody
-
中文名稱:CLDN8兔多克隆抗體
-
貨號:CSB-PA982170
-
規格:¥1100
-
圖片:
-
The image on the left is immunohistochemistry of paraffin-embedded Human liver cancer tissue using CSB-PA982170(CLDN8 Antibody) at dilution 1/50, on the right is treated with synthetic peptide. (Original magnification: ×200)
-
The image on the left is immunohistochemistry of paraffin-embedded Human gastric cancer tissue using CSB-PA982170(CLDN8 Antibody) at dilution 1/50, on the right is treated with synthetic peptide. (Original magnification: ×200)
-
-
其他:
產品詳情
-
Uniprot No.:
-
基因名:CLDN8
-
別名:CLDN8; UNQ779/PRO1573; Claudin-8
-
宿主:Rabbit
-
反應種屬:Human
-
免疫原:Synthetic peptide of Human CLDN8
-
免疫原種屬:Homo sapiens (Human)
-
標記方式:Non-conjugated
-
抗體亞型:IgG
-
純化方式:Antigen affinity purification
-
濃度:It differs from different batches. Please contact us to confirm it.
-
保存緩沖液:-20°C, pH7.4 PBS, 0.05% NaN3, 40% Glycerol
-
產品提供形式:Liquid
-
應用范圍:ELISA,IHC
-
推薦稀釋比:
Application Recommended Dilution ELISA 1:2000-1:5000 IHC 1:50-1:200 -
Protocols:
-
儲存條件:Upon receipt, store at -20°C or -80°C. Avoid repeated freeze.
-
貨期:Basically, we can dispatch the products out in 1-3 working days after receiving your orders. Delivery time maybe differs from different purchasing way or location, please kindly consult your local distributors for specific delivery time.
-
用途:For Research Use Only. Not for use in diagnostic or therapeutic procedures.
相關產品
靶點詳情
-
功能:Tight-junction protein required for paracellular chloride transport in the kidney. Mediates recruitment of CLDN4 to tight junction in the kidney. Claudins play a major role in tight junction-specific obliteration of the intercellular space, through calcium-independent cell-adhesion activity.
-
基因功能參考文獻:
- the present study revealed the distinct expression profiles of claudin5, 7 and 8 in nonneoplastic mucosal tissues and gastric carcinoma tissues. Furthermore, the expression of these claudin proteins was highly associated with metastatic progression and prognosis in patients with gastric carcinoma PMID: 29901188
- data support that the tight junction protein claudin 8 exon 1 is a predictor for the plasma levels of IP-10 in MMT patients with urine test positive for morphine PMID: 29145422
- these results indicate that CLDN8 functions as an androgen receptordownstream signal to facilitate the progression of prostate cancer PMID: 28474805
- Findings suggest a new mechanistic pathway in inflammatory bowel disease in which MiR-223 functions as a proinflammatory molecule targeting CLDN8 in the IL23 pathway. PMID: 27029486
- High Claudin 8 Contributes to Malignant Proliferation in Osteosarcoma. PMID: 26560196
- the expression of claudin-5 and claudin-9 was down-regulated while the expression of claudin-8 was up-regulated in cervical carcinoma tissues compared with adjacent non-neoplastic tissues. PMID: 26464708
- Human Cldn-8 and -14 were shown to convey Clostridium perfringens enterotoxin-mediated cytotoxicity at pathophysiologically relevant concentrations of this toxin, although ~2-to-10-fold less efficiently than Cldn-4. PMID: 23322640
- claudin-7 and claudin-8 have potential use as immunohistochemical biomarkers in the differential diagnosis of chromophobe renal cell carcinoma and oncocytoma PMID: 18799195
- Na(+) absorption is paralleled by claudin-8-mediated sealing of the paracellular barrier to prevent Na(+) back-leakage, supporting steep Na(+) gradients in distal colon. PMID: 19000657
- the combination of CK7, S100A1 and claudin 8 immunohistochemistry can be useful for classifying tumours of overlapping histology as chromophobe renal cell carcinoma or renal oncocytomas. PMID: 19302533
- CLDN8, clustered with CLDN17 at human chromosome 21q22.11, is a four-transmembrane protein with WWCC motif, defined by W-X(17-22)-W-X(2)-C-X(8-10)-C. PMID: 12736707
顯示更多
收起更多
-
亞細胞定位:Cell junction, tight junction. Cell membrane; Multi-pass membrane protein.
-
蛋白家族:Claudin family
-
組織特異性:Expressed in the epididymis, mainly in the caput segment.
-
數據庫鏈接:
Most popular with customers
-
-
YWHAB Recombinant Monoclonal Antibody
Applications: ELISA, WB, IHC, IF, FC
Species Reactivity: Human, Mouse, Rat
-
Phospho-YAP1 (S127) Recombinant Monoclonal Antibody
Applications: ELISA, WB, IHC
Species Reactivity: Human
-
-
-
-
-